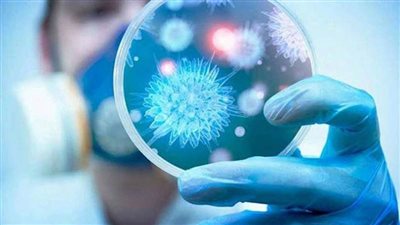
اكتشاف متحور جديد من فيروس كورونا

الأربعاء 21 يناير 2026
الجريدة
الورقية